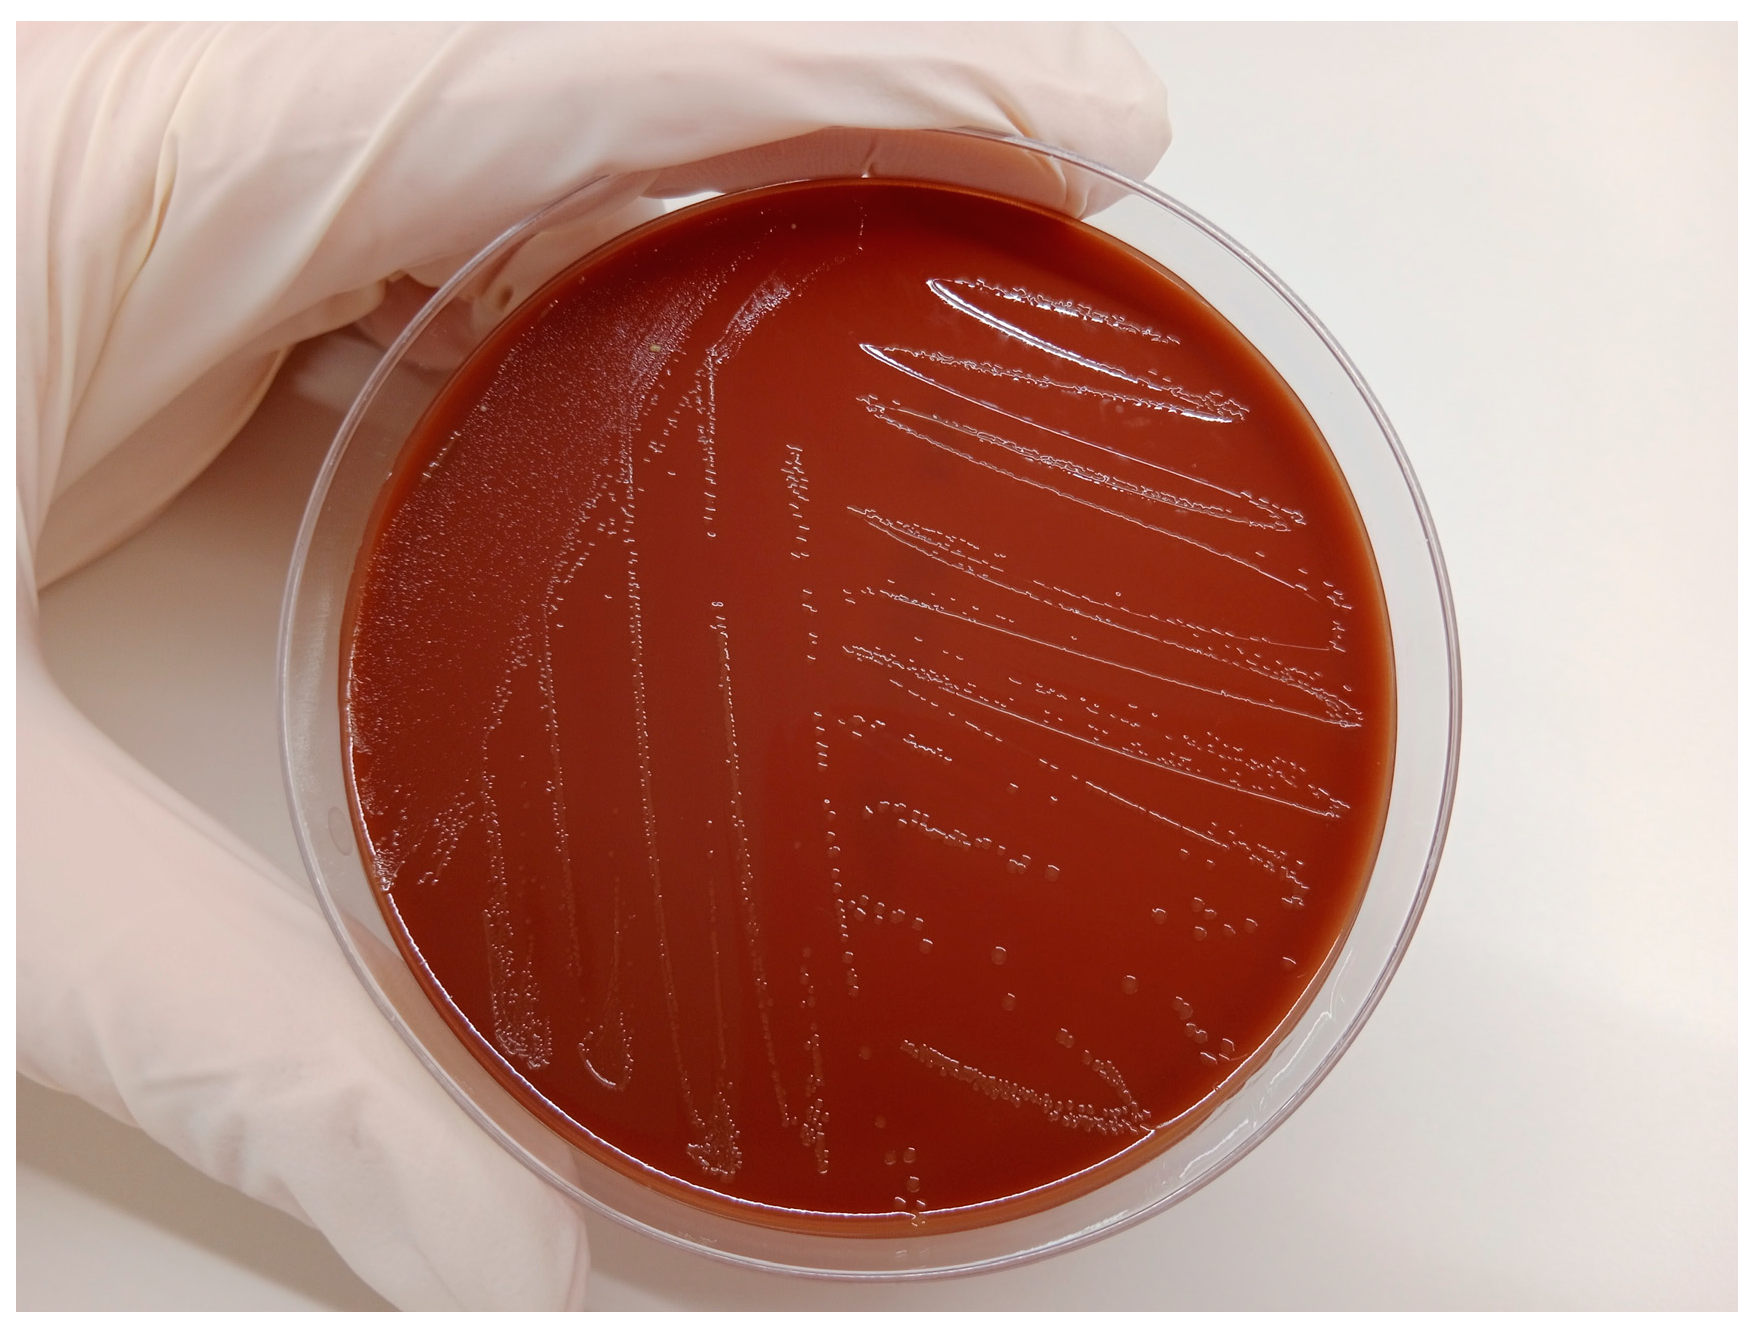
Vetsci 11 00117 g002

1. Introduction
Immediately after calving, bacterial contamination of the uterine lumen is very common [
1]. This fact, combined with local inflammatory phenomena and the cow’s low immune response, means that the possibility of suffering some type of uterine pathology during the first 60 days after parturition is very high [
2].
One of the most common uterine diseases is metritis, pathologically defined as the inflammation of all layers of the uterine wall, showing edema, congestion, infiltration by leukocytes, and myometrial degeneration [
3]. Clinically, two types of metritis can be differentiated: puerperal metritis (PM) and clinical metritis (CM), both of which are characterized by an abnormally enlarged uterus and a fetid watery red-brown uterine discharge within the first 21 days postpartum. However, cows with puerperal metritis show clinical signs associated with systemic illness, including decreased milk yield, dullness, toxemia, and fever (>39.5 °C), and require fast and complete treatment to prevent serious consequences for the animal’s health, occasionally leading to death [
3]. This treatment is usually based on antibiotics and anti-inflammatory and support therapy. Multiple factors may trigger metritis in cattle, such as the calving of twins, dystocia, c-section, retained placenta, hypocalcemia, or ketosis. Furthermore, bacteria may enter the uterus through skin regions, the environment, and iatrogenic contamination can even occur. The bacteria typically associated with uterine diseases are
Escherichia coli,
Trueperella pyogenes,
Fusobacterium necrophorum,
Prevotella spp., and
Bacteroides spp. [
4].
Histophillus somni (H. somni) is a Gram-negative coccobacillus that has been isolated in the respiratory, nervous, and reproductive systems of cattle [
5,
6]. The most frequent clinical expressions are respiratory and neurological disease (including undifferentiated fever, fibrinosuppurative bronchopneumonia, diffuse pleuritis, and thromboembolic meningoencephalitis, followed in some cases by acute myocarditis, polyarthritis/tenosynovitis, abortion with placentitis and fetal septicemia, epididymitis-orchitis, and ocular infections [
6]. Furthermore, it has been described as a commensal and pathogenic organism, and it has also been described as a causative agent involved in infertility and endometritis in cows [
7,
8]. Briefly,
H. somni not only inhibits phagocyte function, but is also cytotoxic for macrophages, and includes other evasive mechanisms such as decreased immune stimulation and antigenic variation [
9].
To the authors’ knowledge, H. somni has never been reported as a unique causative agent of PM in a cow. Therefore, this report describes the clinical and laboratorial diagnosis and treatment of PM in a dairy cow caused by H. somni, which might be a potential pathogen underestimated on farms. Our findings suggest that H. somni should be routinely subjected to laboratory diagnosis of PM in cows and open the door to investigate whether vaccination strategies against H. somni for bovine respiratory disease could be effective to avoid serious uterine infections caused by this microorganism.
2. Case Presentation
A 5-year-old Holstein cow was the case subject. The cow was from a high-production commercial dairy farm located in Catalonia (northeast Spain). The farm was a closed farm, fenced and with restricted and controlled movements of vehicles and persons. The farm was free of BVD and under a strict vaccination program against IBR with a live marked vaccine. The farm milked an average of 700 lactating Holstein cows with an average production of 11,400 kg of milk (3.6% Fat and 3.3% Protein) in 305 days by cows. Cows were housed in five free-stall barns with compost and sawdust bedding: one for high-production multiparous cows, one for low-production multiparous cows, one for first-lactation cows, one for cows between 0 and 21 days in milk, and one for sick cows. All pens guaranteed ≥12m2 of dry bedding/cow, ≥10 cm of drinker/cow, different drinking points, and enough feeding space to avoid competition between cows. Cows were fed an ad libitum total mixed ration consisting of corn silage, grass silage, and concentrate. Cows were milked three times per day in a robotic rotary milking parlor (GEA, Düsseldorf, Germany). All management, clinical examinations, treatments, and artificial inseminations were carried out using a sorting door at the exit of the milking parlor in a specific pen with head lockers designed for these tasks. Cows were never head-locked for more than 20 min.
All cows underwent a general clinical examination carried out by a veterinarian (Lleidavet SLP, Lleida, Spain), including rectal temperature and a review of the data provided by the farm software (Dairy Plan C21 Version 5.3, GEA, Düsseldorf, Germany) every 24 h, rectal palpation, and observation of uterine discharge every Tuesday and Friday between 1 and 30 days postpartum. Uterine discharge was observed through rectal palpation massage to minimize not only contamination of the vagina and uterus but also microtrauma in the area. Quantity, color, proportion of pus, consistency, and smell were evaluated [
3]. Quarterly, samples of uterine contents were taken from cows suffering from uterine disease through uterine lavage and subjected to laboratory diagnosis to identify the pathogens involved and monitor antimicrobial sensitivities. The most common pathogens obtained in past analyses on this farm were
Eschericia coli,
Proteus spp., and
Trueperella pyogenes.
H. somni was never isolated from uterine or vaginal content on this farm before. This farm reports an average of 8% of metritis for the last 5 years (years 2019–2023), calculated as (cases of metritis/number of calvings) × 100.
This farm is endemic of H. somni, since it has been commonly diagnosed on this farm for the last 10 years in routine sampling for BRD in calves and heifers (deep nasal swaps and bronchoalveolar lavage), in combination with Mannheimia haemolytica, Pasteurella multocida, and Mycoplasma bovis. Furthermore, sporadic cases of neurological disease, compatible with histophilosis, have also been clinically diagnosed in youngstock.
The cow was initially diagnosed with PM at day 12 postpartum, when the farm software (Dairy Plan C21 Version 5.3, GEA, Düsseldorf, Germany) alerted to illness suspicion for this cow based on a >40% milk drop for the last 24 h. Clinical examination showed a rectal temperature of 40.4 °C, tachypnea without evidence of respiratory disease at auscultation, moderate dehydration, and uterine discharge, which was completely fluid, brown, and fetid. The cow did not suffer from diarrhea, a displaced abomasum, or ketosis (β-hydroxybutyrate -BHB- concentration in blood = 0.5 mmol/L) (FreeStyle Optium Neo, Abbot Lab, Abbot Park, IL, USA). Subclinical hypocalcemia was not monitored on the farm. The veterinarian took advantage of this case of PM to send routine samples to the laboratory for bacteriological control and antimicrobial sensitivity in metritis cases on the farm. Briefly, samples of uterine content were collected through a sterile catheter with a sterile 25 mL syringe, after cleaning the perineal area with water and neutral pH soap and disinfecting it with alcohol at 70°. Samples were taken directly from the uterus after passing through the uterine cervix.
After sample collection, the cow was treated as protocolized on the farm: oral calcium (Bovicalk, Boehringer Ingelheim, Germany) every 24 h for 2 days in order to treat or prevent hypotetic hypocalcemia and help uterine involution, plus one injection of 37.5 mg of sodium selenium and 1250 mg of α-Tocoferol acetate (Hipravit Selenio, HIPRA, Amer Spain); a non-steroidal anti-inflammatory treatment of meloxicam 0.5mg/Kg of body weight (BW) via a subcutaneous route (Metacam 40 mg/mL, Boehringer Ingelheim, Ingelheim/Rheim, Germany); and an antimicrobial treatment of 15 mg/kg of BW of amoxycillin trihidrate every 48 h by intramuscular route three times (Amoxoil Retard, SYVA, León, Spain). Injections were applied on the neck and the volume of injection was always lower than 20 mL on the same inoculation point. This specific antibiotic was chosen considering previous results of metritis from routine analysis carried out on the farm.
A sample of uterine content was immediately submitted to the laboratory (CONVET, Lleida, Spain) in a 120 mL sterile container under refrigerated conditions (4–8 °C) (
Figure 1 and
Supplementary Material Video S1). The sample was subjected to a microbiological analysis based on plate culture with blood agar and chocolate agar (Biomérieux Ref. 43101, Marcy-l’Etoile, France) for general pathogen identification. These media support the growth of all the bacteria that commonly cause or participate in metritis in cattle [
10,
11]. After the isolation of the microorganism grown on the plate (
Figure 2), a particular identification of
H. somni in the sample was carried out using Matrix-Assisted Laser Desorption/Ionization (Maldi-TOF). A subsequent antimicrobial sensitivity test was conducted using the Kirby–Bauer method from a pure inoculum of the microorganism under study with a turbidity corresponding to the suspension of the MC Farland 0.5 standard, which is equivalent to 1.5 × 10
8 cfu/mL, and the inoculum was seeded in the Mueller–Hinton medium and tested for its susceptibility to antibiotics. In the case of 90 mm diameter Mueller–Hinton agar, a maximum of six disks (each 6 mm in diameter) must be placed with 25 mm between them. Incubation was carried out at 37 °C ± 1 °C in an aerobic O
2 atmosphere for 24 h. In addition to bacterial sensitivity, the laboratory categorizes the antibiotics registered for use in cattle in Spain, to which the bacteria are Sensitive (S), Intermediate (I), or Resistant (R) [
12,
13], and the category to which the antibiotic belongs for its prudent use on farms, according to the National Antibiotic Resistance Plan. This Plan classifies antibiotics in four groups: Group A, not authorized for veterinary use; Group D, cataloged as first choice; Group C, cataloged for precautionary use; Group B, cataloged for restricted use, as they can only be used if there are no Group D or C antimicrobials that can be used in clinical treatment [
14].
4. Discussion
PM is a prevalent uterine disease in dairy cows during the first 21 days postpartum which can directly compromise the cow’s life [
3]. It is assumed that PM is a polymicrobial-caused disease. A wide range of pathogens are described to be causative of metritis in dairy cows, such as
Bacteroides and Fusobacterium [
15]. However, a wide range of other potential pathogens such as
H. somni have occasionally been identified in metritic cows with an uncertain role in the pathogenesis of uterine diseases [
16]. To the authors’ knowledge, this is the first time that
H. somni was isolated as the sole pathogen in a case of PM.
Although culture-based diagnosis may have limitations compared to other techniques for pathogen identification, it is accepted and widely used [
17], above all at an on-farm level during routine and feasible diagnosis. Similarly, the Kirby–Bauer disc diffusion method, although it has limitations compared to other techniques related to antimicrobial resistance and MIC determination, is also a reliable and feasible method to make on-farm decisions about the choice of the use of the best antibiotics to cure animal diseases, but also maximizing the One Health principle. Since we did not find prior results of
H. somni as a single pathogen in positive bovine metritis, and we also did not have an interpretation in the main databases (Clinical and Laboratory Standards Institute -CLSI- and European Committee on Antimicrobial Susceptibility Testing -EUCAST-) for bovine reproductive diseases, we decided to use the Kirby–Bauer technique, and obtained S, I, and R results as an initial study.
Unlike other studies that have investigated the susceptibility of
H. somni to antimicrobials [
18], this clinical case reports the identification of a pathogen resistant to tetracyclines and cephalosporins (Ceftiofur), antibiotics commonly used to treat uterine diseases in dairy cows. This points out the importance of investigating clinical cases routinely to decide the best antimicrobial treatment and to avoid the use of repeating antibiotic treatments not supported by laboratory analysis, which can increase multi-drug resistance in
H. somni and other bacterial agents [
19].
Previous studies have described the consistent presence of
H. somni in the uteruses of healthy cows or cows suffering from uterine pathologies such as vaginitis, cervicitis, metritis, or endometritis [
7,
15,
16]. In a study carried out in South Africa, it seems that the authors also observed the possibility that
H. somni could act as a primary pathogen in these cases [
20]. However, we could not find previous studies that report the isolation of
H. somni as the only pathogen present in PM. As mentioned above,
H. somni was never isolated in any vaginal or uterine content on this farm before. Furthermore, it is quite uncommon to only isolate one bacteria from uterine samples. Fortunately, the laboratory that carries out such routine analyses for this farm always keeps the samples for a period as a “safety method” in case there is a doubt on the results or procedure. In this case, due to the uniqueness of the result (isolation of
H. somni alone, without any other bacteria), the culture was repeated by the laboratory following the same methods, with the same results confirming the findings.
This report describes for the first time a case of PM caused by H. somni as a single primary pathogen. This fact should lead researchers to study as many cases of metritis in cows as possible, including H. somni in laboratory diagnoses on a routine basis, in order to know the real extent of the incidence of this microorganism on uterine diseases in cattle. In the event that the incidence of H. somni is remarkably high or frequent, further research into the use of commercial vaccines destined for the prevention of BRD in cattle, which could perhaps be useful for the prevention of reproductive pathology caused by H. somni in cows, should be considered.